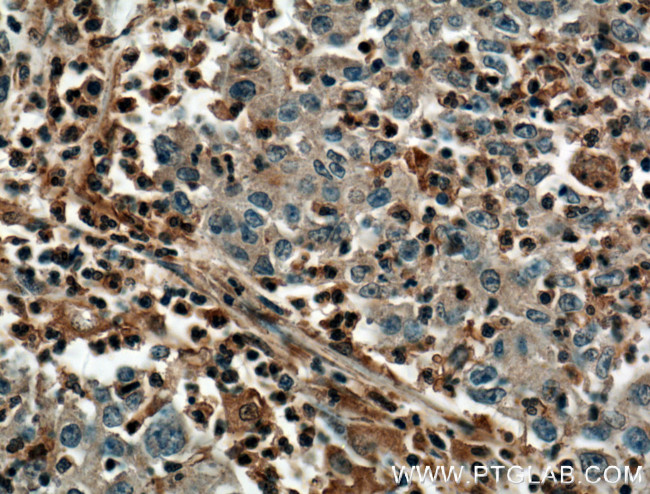
PLEK Antibody in Immunohistochemistry (Paraffin) (IHC (P))

Search
Proteintech
PLEK Monoclonal Antibody (1D5C2)
{{$productOrderCtrl.translations['antibody.pdp.commerceCard.promotion.promotions']}}
{{$productOrderCtrl.translations['antibody.pdp.commerceCard.promotion.viewpromo']}}
{{$productOrderCtrl.translations['antibody.pdp.commerceCard.promotion.promocode']}}: {{promo.promoCode}} {{promo.promoTitle}} {{promo.promoDescription}}. {{$productOrderCtrl.translations['antibody.pdp.commerceCard.promotion.learnmore']}}
产品信息
66431-1-IG
种属反应
宿主/亚型
分类
类型
克隆号
抗原
偶联物
形式
浓度
规格
纯化类型
保存液
内含物
保存条件
运输条件
产品详细信息
Immunogen sequence: MEPKRIREG YLVKKGSVFN TWKPMWVVLL EDGIEFYKKK SDNSPKGMIP LKGSTLTSPC QDFGKRMFVF KITTTKQQDH FFQAAFLEER DAWVRDIKKA IKCIEGGQKF ARKSTRRSIR LPETIDLGAL YLSMKDTEKG IKELNLEKDK KIFNHCFTGN CVIDWLVSNQ SVRNRQEGLM IASSLLNEGY LQPAGDMSKS AVDGTAENPF LDNPDAFYYF PDSGFFCEEN SSDDDVILKE EFRGVIIKQG CLLKQGHRRK NWKVRKFILR EDPAYLHYYD PAGAEDPLGA IHLRGCVVTS VESNSNGRKS EEENLFEIIT ADEVHYFLQA ATPKERTEWI KAIQMASRTG K (1-350 aa encoded by BC018549)
靶标信息
Major protein kinase C substrate of platelets.
仅用于科研。不用于诊断过程。未经明确授权不得转售。
篇参考文献 (0)
生物信息学
蛋白别名: FLJ27168; p47; Platelet 47 kDa protein; Pleckstrin; PLEK; unnamed protein product
基因别名: P47; PLEK; PLEK1
UniProt ID: (Human) P08567
Entrez Gene ID: (Pig) 100516257, (Human) 5341